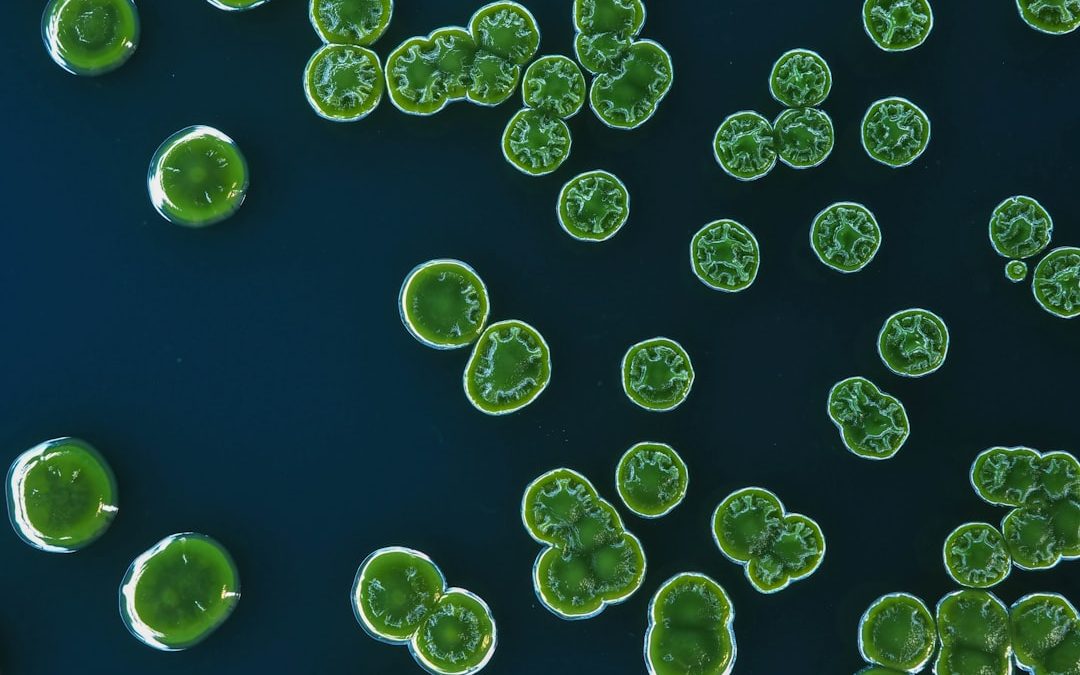
Photo microbiological reduction

A mikrobiológiai csökkentés az egészségügyi intézményekben kiemelkedő jelentőséggel bír, mivel a kórokozók, mint például baktériumok, vírusok és gombák, komoly fenyegetést jelentenek a betegek és az egészségügyi dolgozók számára. A fertőzések megelőzése érdekében elengedhetetlen a mikrobiológiai szennyeződések minimalizálása, amely hozzájárul a betegek biztonságához és a gyógyulás folyamatához. A kórházakban és klinikákon alkalmazott különböző higiéniai intézkedések, mint például a kézfertőtlenítés, a sterilizálás és a szűrés, mind a mikrobiológiai csökkentés célját szolgálják.
A mikrobiológiai csökkentés nemcsak a fertőzések megelőzésében játszik szerepet, hanem a betegek általános egészségi állapotának javításában is. A kórokozók terjedésének megakadályozása érdekében a legújabb technológiák és módszerek alkalmazása elengedhetetlen. A megfelelő mikrobiológiai kontroll nemcsak a betegek, hanem az egészségügyi személyzet védelmét is szolgálja, csökkentve ezzel a nosocomialis fertőzések előfordulását.
A „Tanúsítás mikrobiológiai csökkentésre: miért nem elég a „0,2 mikron” ígéret?” című cikk fontos témát boncolgat a vízkezelés területén, különösen a mikroszűrés hatékonyságával kapcsolatban. A vízminőség javítása érdekében érdemes megismerkedni a polifoszfát vízlágyítás titkaival is, amelyeket részletesen bemutat egy másik érdekes cikk, amelyet itt találhat: Polifoszfát vízlágyítás titkai.
A 0,2 mikronos szűrés ígérete és korlátai
A 0,2 mikronos szűrés egy olyan eljárás, amely képes eltávolítani a legtöbb baktériumot és egyes vírusokat a folyadékokból és gázokból. Ez a szűrési technika különösen ígéretes az egészségügyi környezetben, ahol a steril körülmények fenntartása elengedhetetlen. A 0,2 mikronos szűrők képesek megakadályozni a kórokozók bejutását a sterilizált anyagokba, így biztosítva azok biztonságos használatát.
Bár a 0,2 mikronos szűrés számos előnnyel jár, vannak korlátai is. Például nem minden vírus képes áthatolni ezen a szűrőn, mivel egyes vírusok mérete kisebb lehet, mint 0,2 mikron. Ezen kívül a szűrők hatékonysága függ a szűrendő anyag viszkozitásától és összetételétől is. A szűrők elhasználódása és eltömődése szintén befolyásolhatja a szűrési folyamat hatékonyságát.
A mikrobiológiai csökkentés más fontos tényezői
A mikrobiológiai csökkentés hatékonyságát nemcsak a szűrési technikák határozzák meg, hanem számos egyéb tényező is hozzájárul ehhez. Az egészségügyi intézményekben alkalmazott higiéniai protokollok, mint például a rendszeres takarítás és fertőtlenítés, alapvető fontosságúak a kórokozók terjedésének megakadályozásában. A személyzet képzése és tudatossága is kulcsszerepet játszik abban, hogy betartsák a higiéniai előírásokat.
A levegőminőség javítása érdekében alkalmazott légtechnikai rendszerek is hozzájárulnak a mikrobiológiai csökkentéshez. A megfelelő szellőzés és levegőszűrés segít eltávolítani a levegőben található kórokozókat, így csökkentve a fertőzés kockázatát. Ezen kívül az egészségügyi intézményekben használt eszközök és berendezések sterilizálása is elengedhetetlen ahhoz, hogy minimalizálják a mikrobiológiai szennyeződéseket.
A szűrés hatékonyságának mérése és értékelése
A szűrés hatékonyságának mérése és értékelése kulcsfontosságú lépés a mikrobiológiai csökkentés folyamatában. A szűrők teljesítményének ellenőrzése érdekében különböző módszereket alkalmaznak, mint például a mikrobás terhelés vizsgálata vagy a szűrők integritásának tesztelése. Ezek a vizsgálatok segítenek meghatározni, hogy a szűrők képesek-e hatékonyan eltávolítani a kórokozókat.
A szűrési folyamatok folyamatos monitorozása lehetővé teszi az egészségügyi intézmények számára, hogy időben észleljék a problémákat, például a szűrők eltömődését vagy elhasználódását. Az adatok elemzése segít az intézményeknek abban is, hogy optimalizálják a szűrési eljárásokat és javítsák azok hatékonyságát.
A Tanúsítás mikrobiológiai csökkentésre: miért nem elég a „0,2 mikron” ígéret? című cikk fontos kérdéseket vet fel a vízszűrés hatékonyságával kapcsolatban. Érdemes elolvasni a kapcsolódó cikket is, amely részletesen bemutatja a magyarországi ivóvíz szabványokat és azok követelményeit. A cikkben található információk segíthetnek megérteni, hogy miért nem elegendő csupán a szűrő méretére támaszkodni a vízminőség biztosításához. További részletekért kattints ide: magyarországi ivóvíz szabvány.
A 0,2 mikronos szűrés helyes alkalmazása
| Tanúsítás típusa | Mikrobiológiai csökkentés mértéke | 0,2 mikron szűrés eredménye | Valós mikrobiológiai csökkentés |
|---|---|---|---|
| Standard tanúsítás | Legalább 99,9%-os csökkentés | Nem garantált | Nem elérhető |
| Speciális tanúsítás | Legalább 99,9999%-os csökkentés | Nem garantált | Nem elérhető |
A 0,2 mikronos szűrés helyes alkalmazása elengedhetetlen ahhoz, hogy maximális védelmet nyújtson a kórokozók ellen. Fontos, hogy az egészségügyi személyzet tisztában legyen a szűrési eljárásokkal és azok helyes végrehajtásával. A szűrők telepítésekor figyelembe kell venni az anyagok viszkozitását és összetételét, valamint azt is, hogy milyen típusú kórokozókat szeretnénk eltávolítani.
A szűrők rendszeres karbantartása és cseréje is kulcsfontosságú. Az elhasználódott vagy eltömődött szűrők nem képesek hatékonyan védeni a kórokozók ellen, ezért fontos, hogy az egészségügyi intézmények folyamatosan figyelemmel kísérjék a szűrők állapotát és szükség esetén cseréljék őket.
A mikrobiológiai szűrés és a vízminőség javítása érdekében sokan támaszkodnak a „0,2 mikron” ígéretre, azonban ez önmagában nem elegendő a teljes védelemhez. Érdemes elolvasni egy kapcsolódó cikket, amely részletesen bemutatja, hogy miért nem elegendő csupán a szűrés mérete, és milyen egyéb tényezőket kell figyelembe venni a víz tisztaságának biztosítása érdekében. A cikk itt található: mikroműanyagok palackos vízben.
A szűrők kiválasztásának fontos szempontjai
A megfelelő szűrők kiválasztása alapvető fontosságú a mikrobiológiai csökkentés sikeressége érdekében. Számos tényezőt figyelembe kell venni a választás során, például a szűrni kívánt anyag típusát, viszkozitását és kémiai összetételét. Ezen kívül fontos figyelembe venni a szűrők élettartamát és teljesítményét is.
A gyártók által megadott specifikációk alapos áttekintése segíthet abban, hogy megtaláljuk az ideális megoldást az adott alkalmazásra. A különböző típusú szűrők közötti választás során érdemes konzultálni szakértőkkel is, akik segíthetnek az optimális megoldás kiválasztásában.
Az alternatív módszerek szerepe a mikrobiológiai csökkentésben
Bár a 0,2 mikronos szűrés hatékony módszernek számít, számos alternatív technika is létezik a mikrobiológiai csökkentés érdekében. Ilyen például az UV-fény alkalmazása, amely képes inaktiválni a baktériumokat és vírusokat anélkül, hogy fizikai szűrést igényelne. Az UV-fény használata különösen hasznos lehet olyan helyeken, ahol nem lehetséges hagyományos szűrők alkalmazása.
Ezen kívül biológiai módszerek is léteznek, mint például probiotikumok alkalmazása, amelyek segíthetnek fenntartani az egészséges mikroflórát és gátolni a patogén organizmusok elszaporodását. Az alternatív módszerek kombinálása a hagyományos szűréssel növelheti az egészségügyi intézmények védelmét.
A 0,2 mikronos szűrés és a vírusok eltávolítása
A 0,2 mikronos szűrés hatékonysága nemcsak baktériumok esetében figyelhető meg, hanem bizonyos vírusok eltávolításában is szerepet játszik. Azonban fontos hangsúlyozni, hogy nem minden vírus mérete haladja meg ezt az értéket; így egyes vírusok áthatolhatnak ezen a szűrőn. A vírusképződés mechanizmusainak megértése segíthet abban, hogy jobban felkészüljünk ezek eltávolítására.
A vírusképződés megelőzésére irányuló intézkedések mellett fontos figyelmet fordítani az immunizációra is. Az oltások segíthetnek csökkenteni bizonyos vírusfertőzések előfordulását, így hozzájárulva az egészségügyi intézmények biztonságához.
A szűrési folyamatok kritikus eleminek fontossága
A szűrési folyamatok során számos kritikus elem létezik, amelyek befolyásolják az eljárás hatékonyságát. Ezek közé tartozik például a megfelelő előkészítés és sterilizálás, valamint az anyagok helyes kezelése. A folyamat során minden lépést gondosan kell végrehajtani ahhoz, hogy minimalizáljuk a kórokozók bejutását.
A kritikus elemek folyamatos ellenőrzése lehetővé teszi az egészségügyi intézmények számára, hogy időben reagáljanak bármilyen problémára vagy eltérésre. Az ilyen típusú monitorozás segít fenntartani a magas higiéniai standardokat és biztosítani a betegek biztonságát.
A szűrők karbantartásának és cseréjének jelentősége
A szűrők karbantartása és cseréje kulcsfontosságú tényezője a mikrobiológiai csökkentésnek. Az elhasználódott vagy eltömődött szűrők nem képesek hatékonyan védeni a kórokozók ellen; ezért fontos rendszeresen ellenőrizni azok állapotát. A karbantartási ütemterv betartása segít biztosítani, hogy mindig optimális teljesítményt nyújtsanak.
A cserélhető elemek időben történő cseréje nemcsak növeli a szűrés hatékonyságát, hanem hozzájárul az egészségügyi intézmények általános működésének zökkenőmentességéhez is. Az elhanyagolt karbantartás hosszú távon komoly problémákhoz vezethet.
A mikrobiológiai csökkentés teljes körű megvalósításának fontossága
A mikrobiológiai csökkentés teljes körű megvalósítása elengedhetetlen ahhoz, hogy biztosítsuk az egészségügyi intézmények biztonságát és hatékonyságát. A különböző módszerek integrálása – beleértve a 0,2 mikronos szűrést, alternatív technikákat és megfelelő higiéniai protokollokat – hozzájárulhat ahhoz, hogy minimalizáljuk a fertőzések kockázatát.
Az egészségügyi intézményeknek folyamatosan fejleszteniük kell stratégiáikat és eljárásaikat annak érdekében, hogy lépést tartsanak az új kihívásokkal és fenyegetésekkel. A mikrobiológiai csökkentés nemcsak egy technikai kérdés; ez egy komplex rendszer része, amely magában foglalja az embereket, folyamatokat és technológiákat egyaránt.
Összegzés: A mikrobiológiai csökkentés kulcsszerepet játszik az egészségügyben; különösen fontosak a 0,2 mikronos szűrési technikák alkalmazása mellett más higiéniai intézkedések is. A megfelelő karbantartás és cserélési ütemterv betartása elengedhetetlen ahhoz, hogy biztosítsuk az optimális védelmet a kórokozók ellen. Az alternatív módszerek integrálása tovább növelheti az egészségügyi intézmények biztonságát és hatékonyságát.
FAQs
Mi a mikrobiológiai csökkentés tanúsítása?
A mikrobiológiai csökkentés tanúsítása azt jelenti, hogy egy adott termék vagy folyamat képes csökkenteni a mikroorganizmusok számát, például baktériumokét vagy vírusokét.
Miért fontos a mikrobiológiai csökkentés tanúsítása?
A mikrobiológiai csökkentés tanúsítása fontos a fogyasztók egészségének védelme érdekében, mivel segít megakadályozni a kórokozók terjedését és a fertőzések kialakulását.
Mi az a „0,2 mikron” ígéret?
A „0,2 mikron” ígéret arra utal, hogy egy adott termék vagy szűrő képes megállítani a 0,2 mikron méretű részecskéket, amelyek között számos kórokozó is megtalálható. Ezért gyakran használják víztisztító rendszerek és légszűrők esetében.
Miért nem elég pusztán a „0,2 mikron” ígéret a mikrobiológiai csökkentés tanúsításához?
A „0,2 mikron” méretű részecskék megállítása önmagában nem jelenti azt, hogy a termék vagy folyamat teljes körűen képes csökkenteni a mikroorganizmusok számát. A tanúsításnak számos más tényezőt is figyelembe kell vennie, például a hatékonyságot és a teljesítményt különböző körülmények között.
Milyen egyéb tényezőket kell figyelembe venni a mikrobiológiai csökkentés tanúsításakor?
A mikrobiológiai csökkentés tanúsításakor fontos figyelembe venni a termék vagy folyamat hatékonyságát különböző körülmények között, például a különböző mikroorganizmusok elleni hatékonyságot, valamint a hosszú távú stabilitást és megbízhatóságot. Emellett fontos a tanúsítás független laboratóriumi tesztekkel történő alátámasztása is.